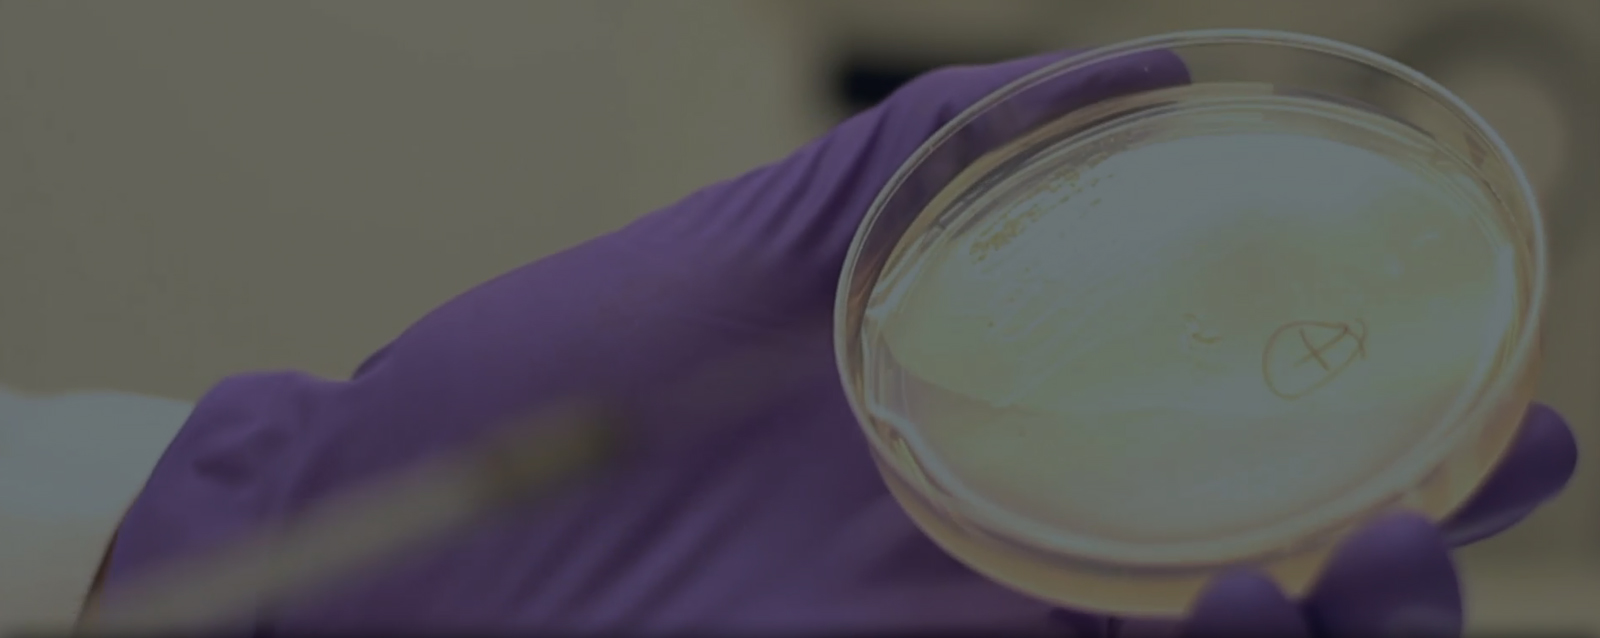
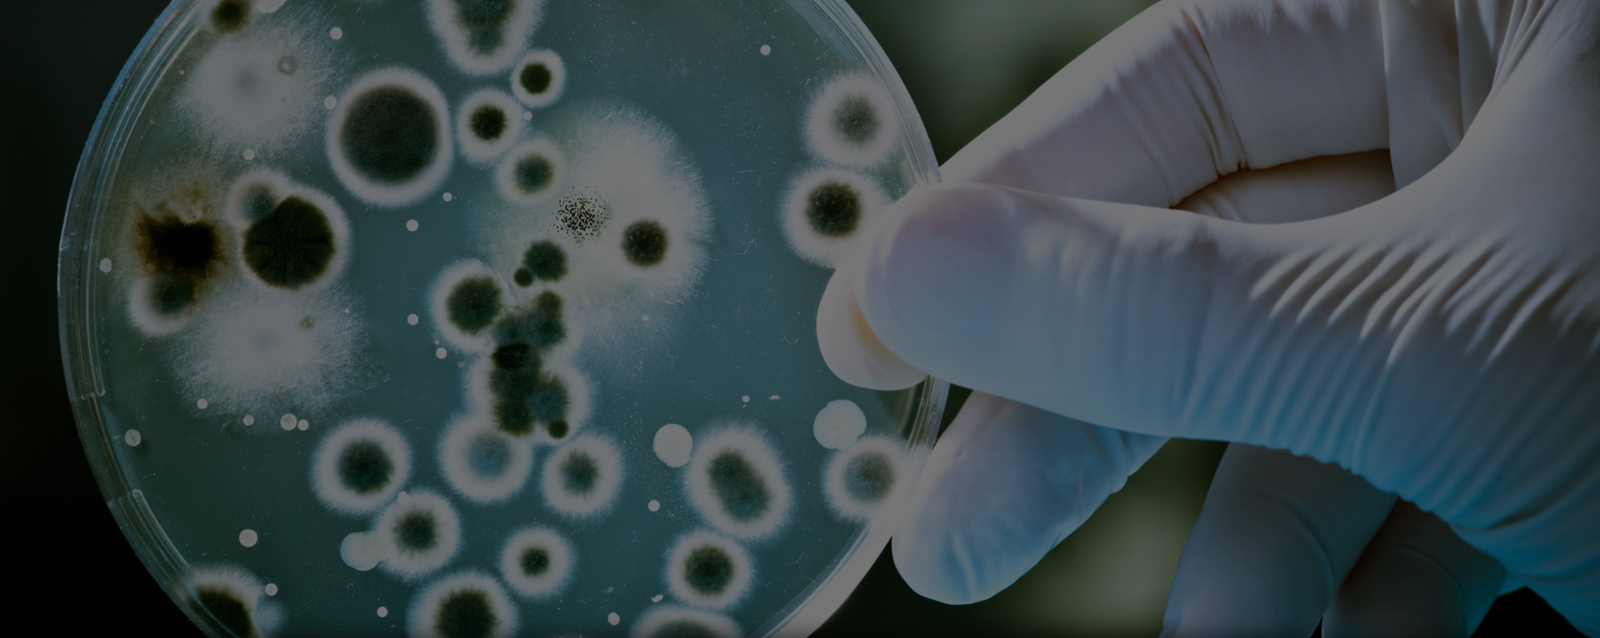

The hospital antibiogram is a periodic summary of antimicrobial susceptibilities of local bacterial isolates submitted to the hospital's clinical microbiology laboratory.
Antibiograms are used by clinicians to assess local susceptibility rates, as an aid in selecting empiric antibiotic therapy, and in monitoring resistance trends over time within an hospital. Antibiograms can also used to compare susceptibility rates across institutions and track resistance trends.
National Treatment Guidelines for Antimicrobial Use in Infectious Diseases issued by Ministry of Health & Family Welfare, Government of India stressed to use hospital guidelines based on local antibiograms when choosing antimicrobial therapy.
